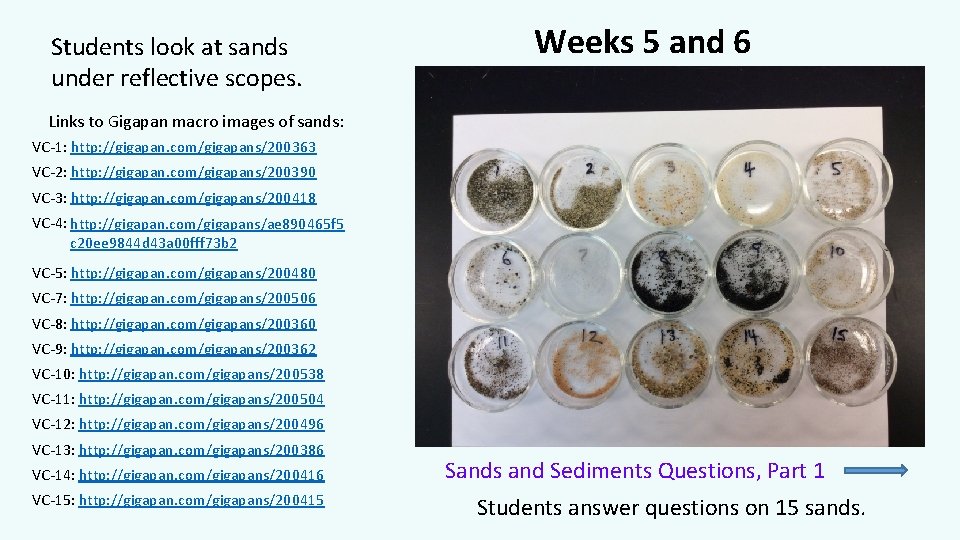
Students look at sands under reflective scopes. Weeks 5 and 6 Links to Gigapan

Evaluating Sands using Remotely Operated Scanning Electron Microscope










- Slides: 10

Evaluating Sands using Remotely. Operated Scanning Electron Microscope Mary Beck (Valencia College, Orlando FL, mbeck 2@valenciacollege. edu) Christopher Vidito (Florida Center for Analytical Electron Microscopy, Florida International University, Miami FL, cvidito@fiu. edu) Jeffrey Ryan (University of South Florida, Tampa FL, ryan@mail. usf. edu) Rosemary Hickey-Vargas (Florida International University, Miami FL, hickey@fiu. edu) James Mac. Donald (Florida Gulf Coast University, Fort Myers FL, jmcdonal@fgcu. edu) MSI-REa. CH

NSF TUES 2 Project: Expanding the Use of Online Remote Electron Microscopy in the Classroom to Transform Undergraduate Geoscience Education Valencia College Project: • 2 -year college • Hispanic Serving Institution (HSI) • Non-majors, non-lab introductory earth science class • Class enrollment cap of 24 students • Meets 1 x/week for 2. 75 hours • Focus on sands

Week 1: Students collected campus sands. (http: //gigapan. com/gigapans/200382) Valencia College sand: hand lens and reflective scope Weeks 5 & 6 (rocks/minerals and weathering) 15 sands: reflective scope and EDS/provenance Weeks 7 & 8 (geologic time and mass movement) 15 sands: SEM/depositional environment Weeks 12 & 13 (weather and climate) ODP samples: SEM/ice-rafting mechanism Week 14 (climate) Valencia College sand: SEM/depositional environment
Students look at sands under reflective scopes. Weeks 5 and 6 Links to Gigapan macro images of sands: VC-1: http: //gigapan. com/gigapans/200363 VC-2: http: //gigapan. com/gigapans/200390 VC-3: http: //gigapan. com/gigapans/200418 VC-4: http: //gigapan. com/gigapans/ae 890465 f 5 c 20 ee 9844 d 43 a 00 fff 73 b 2 VC-5: http: //gigapan. com/gigapans/200480 VC-7: http: //gigapan. com/gigapans/200506 VC-8: http: //gigapan. com/gigapans/200360 VC-9: http: //gigapan. com/gigapans/200362 VC-10: http: //gigapan. com/gigapans/200538 VC-11: http: //gigapan. com/gigapans/200504 VC-12: http: //gigapan. com/gigapans/200496 VC-13: http: //gigapan. com/gigapans/200386 VC-14: http: //gigapan. com/gigapans/200416 VC-15: http: //gigapan. com/gigapans/200415 Sands and Sediments Questions, Part 1 Students answer questions on 15 sands.

Mineral Kit Rock Kit

Weeks 5 and 6: Analyze composition using EDS Report Students report on EDS work. Spectrum image: Chris Vidito, FCAEM

Weeks 7 and 8: Students use Vos et al. , 2014 and quartz sand texture descriptors to determine likely environment of sand deposition. Vos Quartz Sand Surface Textures Tally Students report on SEM work. Sands and Sediments Questions, Part 2 Students report investigation results.

Weeks 12 and 13: Students use SEM and quartz texture micro images (St. John, et al. , 2015) to distinguish between IRD (iceberg-rafted debris) and SIRD (sea ice-rafted debris). ODP Quartz Grain Microfeatures Tally Sheet and Histograms

Week 14: Revisit Valencia College Sand.

Acknowledgements Kristen St. John and MSI REa. CH (Reconstructing Earth’s Climate History) Robin Rohrback at Northern Virginia Community College References St. John, K. , Passchier, S. , Tantillo, B. , Darby, D. , and Kearns, L. , 2015, Microfeatures of modern sea-ice-rafted sediment and implications for paleo-sea-ice reconstructions. Annals of Glaciology, v. 56, no. 69, p. 83 -93. https: //www. igsoc. org/annals/56/69/a 69 a 586_rgb. pdf Vos, K. , Vandenberghe, N. , and Elsena, J. , 2014, Surface textural analysis of quartz grains by scanning electron microscopy (SEM): From sample preparation to environmental interpretation. Earth-Science Reviews, v. 128, p. 93– 104. https: //www. researchgate. net/publication/259086698_Surface_textural_analysis_of_quar tz_grains_by_scanning_electron_microscopy_SEM_From_sample_preparation_to_environ mental_interpretation